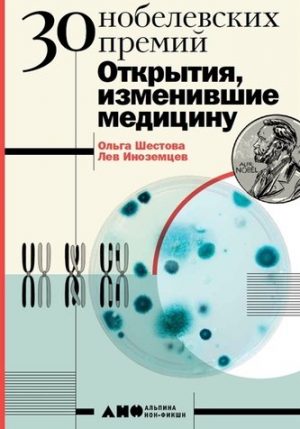

Showing 109–144 of 8288 results
-

250 лучших головоломок от великого Шерлока Холмса
€5,99 Быстрый просмотр -

250 лучших игр и головоломок на каникулах
€5,99 Быстрый просмотр -

250 лучших логических игр и головоломок
€5,99 Быстрый просмотр -

2500 задач по математике. 1-4 классы
€2,99 Быстрый просмотр -

280 дней до вашего рождения Репортаж о том, что вы забыли, находясь в эпицентре событий
€9,99 Быстрый просмотр -

29 отравленных принцев
€2,99 Быстрый просмотр -

3+ 100 окошек — открывай-ка!
€14,99 Быстрый просмотр -

30 стройных дней План по созданию фигуры твоей мечты
€14,99 Быстрый просмотр -

30 шикарных дней. План по созданию жизни твоей мечты
€9,99 Быстрый просмотр -
30 нобелевских премий: Открытия, изменившие медицину
€9,99 Быстрый просмотр -

30 шикарных дней План по созданию жизни твоей мечты
€14,99 Быстрый просмотр -

3000 английских слов. Техника запоминания
€3,99 Быстрый просмотр -

3000 картинок Космос и Земля, которые можно рассматривать целый год
€19,99 Быстрый просмотр -

3000 картинок. Динозавры и Животные, которые можно рассматривать целый год
€19,99 Быстрый просмотр -
Sale!

301 история о веселых гномах
Original price was: €14,99.€11,99Current price is: €11,99. Быстрый просмотр -

301 история о забавных слонах
€14,99 Быстрый просмотр -
Sale!

301 история о лесных медведях
Original price was: €14,99.€11,99Current price is: €11,99. Быстрый просмотр -

301 история о пушистых кроликах
€14,99 Быстрый просмотр -

301 история о ловких котах
€14,99 Быстрый просмотр -
Sale!

301 история об озорных мышах
Original price was: €14,99.€11,99Current price is: €11,99. Быстрый просмотр -

365 советов на первый год жизни вашего ребенка
€14,99 Быстрый просмотр -

365 крутых экспериментов
€9,99 Быстрый просмотр -

365 сказок на круглый год
€14,99 Быстрый просмотр -

365 сказок на ночь
€14,99 Быстрый просмотр -

365 стихов для детского сада
€9,99 Быстрый просмотр -

38 попугаев
€14,99 Быстрый просмотр -

38 попугаев
€6,99 Быстрый просмотр -

38 попугаев
€3,99 Быстрый просмотр -

38 попугаев. Сказки для маленьких детей
€9,99 Быстрый просмотр -

419
€8,99 Быстрый просмотр -

4321
€14,99 Быстрый просмотр -

45 оттенков зеленого Здоровые рецепты и красивые блюда Для вегетарианцев и не только
€9,99 Быстрый просмотр -

45 татуировок личности Правила моей жизни
€19,99 Быстрый просмотр -

45 татуировок менеджера. Правила российского руководителя под партнерством ISpring
€19,99 Быстрый просмотр -

450 лет лидерства: Технологический расцвет Голландии в XIV-XVIII вв. и что за ним последовало
€24,99 Быстрый просмотр -

451′ по Фаренгейту
€3,99 Быстрый просмотр
